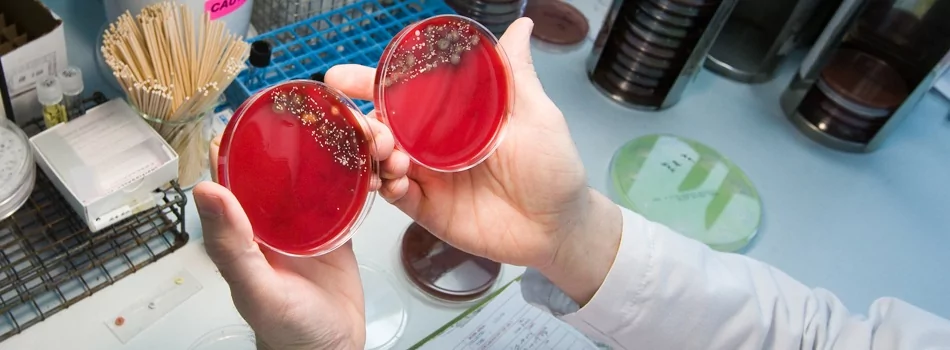

Что такое остеомиелит?
Остеомиелит представляет собой гнойное инфекционное заболевание, которое развивается в костном мозге и кости, затрагивая окружающие мягкие ткани. Различают как острый, так и хронический остеомиелит тазобедренного сустава. Острым он называется в том случае, если проявился впервые, хроническим — давно протекающий с периодическими обострениями.
Провоцируют появление остеомиелита пиогенные бактерии, то есть бактерии, вызывающие гнойные воспаления. В редких случаях это заболевание носит не инфекционный характер и развивается на фоне резкого снижения иммунной системы организма, например, из-за переохлаждения или нарушения кровоснабжения. Такой остемиелит называют гематогенным.
Также бывает посттравматическая причина, когда в результате открытого перелома или при гнойных осложнениях, возникших после оперативного вмешательства, развивается экзогенный остеомиелит.
Может поразить абсолютно любую кость человеческого организма, но наиболее часто встречается на следующих участках:
- на плечах;
- бедрах;
- позвоночнике;
- челюсти.
Возникает чаще всего у мужчин, стариков и детей из-за более частого получения различного рода травм и особенностей иммунитета.
Симптомы
В зависимости от возраста и возбудителя инфекции симптомы могут различаться. Выделяют 3 формы развития острого остеомиелита:
- Септико-пиемическая форма, которая включает в себя резкое повышение температуры тела от 38°С, упадок сил и прочие проявления интоксикации организма. Также развитие болезни может сопровождаться рвотой и головными болями. Возникают сильные боли в области воспаления. Появляется полное ограничение движений. Окружающие мягкие ткани значительно опухают, появляется покраснение.
- Местная форма. Преобладают местные проявления болезни. Интоксикация значительно меньше, чем при септико-пиемической форме, либо вовсе отсутствует.
- Токсическая. При такой форме заболевания процесс развития септического состояния происходит очень быстро. Прогноз на выздоровление неблагоприятный. Встречается токсическая форма крайне редко.
Если гнойник самостоятельно вскрывается, на коже образуется свищ. Через него выходит гной и секвестры — части костей. Самочувствие больного улучшается. Острая форма болезни переходит в хронический остеомиелит.
Для хронического остеомиелита характерны следующие признаки:
- Самочувствие в фазе ремиссии нормальное, больного практически ничего не беспокоит.
- Анализы, сделанные во время ремиссии, могут не показать интоксикации организма и воспалений.
- В момент обострения температура тела не поднимается выше 38°С.
- Могут сохраняться отеки и покраснения в местах поражения.
- На бедрах появляются свищи.
Помимо острого и хронического остеомиелита существует еще несколько форм болезни:
- альбуминозный остеомиелит Оллье;
- склерозирующий остеомиелит Гарре.
С такими видами зачастую путают такие заболевания как остеома бедренной кости и абсцесс Броди. По своему протеканию напоминает острую стадию болезни, но в более мягкой форме.
Диагностика и лечение
При малейшем подозрении на данное заболевание больного срочно госпитализируют в травматологическое или отделение гнойной хирургии. Лечением должны заниматься одновременно несколько специалистов:
- травматологи;
- ортопеды;
- хирурги.
После осмотра пациента врачи назначают ряд исследований. Первоначально сдаются анализы, назначаемые при любой госпитализации:
- общий анализ крови;
- биохимический;
- общий анализ мочи.
Далее назначаются рентгенография и компьютерная томография костей таза.
И как можно раньше больному проводят следующие процедуры:
- Начинают внутривенно вводить антибиотики.
- Переливают плазму и дезинтоксикационные кровезаменители.
- Колют иммуностимуляторы и витамины.
- Искусственно очищают кровь от токсических веществ — гемосорбция.
Больную конечность иммобилизируют — обездвиживают при помощи гипсовой лангетки. Назначают физиопроцедуры. А на первоначальных стадиях, когда процесс гниения еще не распространился за пределами кости, делают трепанацию.
Прогноз на выздоровление
Выздоровление пациента напрямую зависит от формы заболевания, насколько рано оно было выявлено и правильно ли лечится. В целом прогноз на выздоровление благоприятный. Осложняется у детей и стариков, а также у людей с застарелой формой болезни.
По статистике больше половины вовремя прооперированных людей не сталкиваются с рецидивами на протяжении четырех и более лет
Поэтому очень важно при малейшем подозрении на остеомиелит как можно скорее обратиться к врачу и строго соблюдать все назначения
Хронический остеомиелит
В подавляющем большинстве случаев второй является следствием запущенного острого остеомиелита и развивается при сохранении симптомов больше 4—6 месяцев, хотя предпосылки для его возникновения закладываются уже спустя 0,5—1,5 месяца после начала воспалительного процесса.
При хроническом остеомиелите наблюдаются четко отграниченные от других тканей гнойники и секвестры. При этом в них есть специфические отверстия, посредством которых они сообщаются с мягкими тканями и свищами. Это сопряжено с прогрессированием остеопороза, остеосклероза, а также создает предпосылки для деформации кости.
Характеризуется чередованием периодом затухания симптомов (ремиссий) и обострений. Последние могут вызвать существенные физические нагрузки, присутствие инфекций в организме или ослабление защитных сил пациента в результате действия других факторов. Выраженность болей и системных реакций наименее выражена, причем после открытия свища состояние улучшается и практически нормализуется.
Переход инфекции в хроническую форму наблюдается у 10—30% детей. В таком случае обострения уже могут случаться и во взрослом возрасте.
Симптомы остеомиелита нижних конечностей
Начальные признаки заболевания обычно не являются специфичными и могут напоминать банальную простуду. При этом у человека повышается температура, ухудшается аппетит, появляются боли в мышцах. Недомогание постепенно нарастает. Появляются местные симптомы:
- выраженный болевой синдром локального характера — боли грызущие, распирающие, не поддающиеся действию обезболивающих препаратов, усиливающиеся по ночам и при нагрузке;
- покраснение кожи над пораженным участком, повышение местной температуры;
- отечность мягких тканей в области воспалительного очага, которая быстро нарастает и постепенно распространяется на весь сегмент конечности.
Локальные изменения происходят на фоне общих проявлений интоксикации: выраженная лихорадка, головная боль, тошнота, рвота, гипотония, аритмия.
Гной постепенно накапливается, вызывая отслоение надкостницы. Выделение микробами ферментов, разлагающих ткани, продолжается. Поэтому формируются свищи, через которые выделяется скопившийся гнойный экссудат. Это дает облегчение пациенту, боли становятся менее интенсивными.
При переходе в хроническую форму проявления болезни меняются. Интоксикация выражена меньше, температура подскакивает только при обострениях. Местные симптомы заключаются в периодическом выделении гнойного содержимого из свищевого хода, что приводит к улучшению самочувствия.
Каждый десятый пациент первоначально обратился по поводу инфекционных болезней или гнойных очагов кожи, мягких тканей или внутренних органов. Примерно каждый пятый случай заболевания сложно связать с какой-либо причиной.
Воспаление бедра
Бедренная кость может быть поражена вследствие травмы, операции, при попадании микробов с током крови или лимфы. Процесс имеет тенденцию распространяться на прилегающие суставы. Поэтому у пациентов часто возникают гнойные артриты в области колена и тазобедренного сочленения. Воспаление постепенно захватывает не только костные ткани, но и костно-мозговой канал.
Остеомиелит тазобедренного сустава
Причинами возникновения патологии такой локализации являются: перелом шейки бедра, бедренной кости, осложнения при ортопедической операции.
Остеомиелит тазобедренного сустава имеет следующие симптомы:
- интенсивная боль, распространяющаяся на бедро и соответствующую половину таза;
- резкое уменьшение объема пассивных и активных движений в суставе, вплоть до их полного отсутствия;
- выраженные проявления интоксикации.
Консервативная терапия не эффективна, она лишь может привести к хронизации процесса. При этом головка бедра постепенно разрушается. Выраженный болевой синдром лишает человека сна, сустав теряет свою функцию, движения в нем становятся невозможными.
Восстановить способность самостоятельно передвигаться и обслуживать себя поможет только эндопротезирование.
Симптомы поражения голени и коленного сустава
Наиболее частой причиной заражения являются травматические повреждения. Обычно переломам подвержена большеберцовая кость. Остеомиелит коленного сустава может возникнуть также после эндопротезирования при нарушениях правил антисептики или сниженной иммунной системы пациента.
При развитии патологии появляются следующие признаки:
- боль в пораженном участке ноги;
- мышечный спазм, вынуждающий пациента держать конечность в согнутом положении;
- горячая, отечная и красная кожа над очагом воспаления;
- выраженные симптомы интоксикации.
Постепенно процесс захватывает малоберцовую кость. Наиболее демонстративно протекает воспаление колена и голеностопного сочленения у пожилых людей.
Остеомиелит данной локализации отличается склонностью к переходу в хроническую форму. С годами у человека деформируются голень и колено, движения становятся болезненными и ограниченными, нога — короче.
Воспаление голеностопного сустава и стопы
Остеомиелит стопы наиболее часто развивается у людей, страдающих сахарным диабетом. При недостаточной коррекции уровня сахара в крови развивается диабетическая полинейропатия. При этом нарушается чувствительность в области стопы, снижаются ахилловы рефлексы.
На фоне значительных изменений метаболизма и микроциркуляции формируются трофические язвы. Некротический процесс обычно захватывает не только мягкие ткани, но и пяточную, плюсневые кости. Часто страдают фаланги пальцев.
Огнестрельный остеомиелит
Остеомиелит часто развивается в глубоких тканях и костях. Эмоциональный стресс, низкий иммунитет и неадекватная обработка ран могут стать причиной этого заболевания. Обычно присутствуют и признаки посттравматического остеомиелита. При огнестрельном остеомиелите припухлость в области поражения обычно незначительная, гноя в большом количестве не обнаруживается. Область вокруг раны может выглядеть тусклой с сероватым налетом, что свидетельствует о распространении инфекции на каждый слой кости. В редких случаях, при значительном раздроблении или смещении костей, в костной мозоли появляются гнойные очаги.
Послеоперационный остеомиелит
Как правило, этот вид посттравматического остеомиелита является результатом неудачной асептической процедуры или высокоинвазивной операции, такой как остеосинтез закрытых переломов, ортопедические операции, установка штифтов в компрессионно-дистракционных аппаратах или скелетное вытяжение.
Контактный остеомиелит
Инфицирование кости часто является следствием гнойных процессов в прилегающих мягких тканях. В частности, к этому могут привести панариции, абсцессы и флегмоны кисти, а также большие раны на голове. Симптомами являются отек, повышенная болезненность в области повреждения и образование свищей.
Лечение
Пациенты с острым остеомиелитом должны госпитализироваться в травматологическое отделение. Иммобилизация конечности является обязательным условием лечения. Необходимо начать курс антибиотиков с учетом чувствительности бактерий. Для снижения токсичности, восполнения объема крови и улучшения местного кровообращения необходимо переливание плазмы, гемодеза и 10% раствора альбумина.
При сепсисе может быть использована экстракорпоральная гемокоррекция путем гемосорбции и лимфосорбции. Кроме того, решающее значение для успешного лечения имеет дренирование гнойного очага, для чего на ранних стадиях в кости делаются трепанационные отверстия с последующим промыванием растворами антибиотиков и протеолитических ферментов.
Механизм развития
Все еще нет единого мнения о том, каким же именно образом начинает развиваться воспалительный процесс в кости. В настоящее время существует несколько независимых теорий, объясняющих процесс зарождения инфекционного воспаления в костной ткани. Самыми актуальными из которых являются:
- Сосудистая. Костные капилляры образуют хорошо развитую сосудистую сеть, однако это способствует снижению общей скорости кровотока в них. При наличии бактерий в кровяном русле они оседают на костной ткани с последующим формированием остеомиелита.
- Аллергическая. Суть этой теории в том, что сенсибилизация организма провоцирует развитие асептического воспаления и отека в околососудистой клетчатке при любом травматическом воздействии. Далее происходит сдавление сосудов, ухудшение кровообращения с прогрессированием отека. Попадание микроорганизмов в такой очаг вызывает гнойно-воспалительное поражение.
- Нервно-рефлекторная. Любое нервное напряжение провоцирует спазм сосудов с последующим нарушением кровообращения и развитием очагов некроза в кости. Присоединение бактериальной инфекции ведет к развитию заболевания.
Дальнейшее течение заболевания типично: патогенная микрофлора начинает активно размножаться в костномозговом канале с формированием воспаления и гноеобразованием. При этом повышается внутрикостное давление. Дальнейшее распространение гноя может производиться несколькими путями:
- В направлении эпифиза (окончания кости) с последующим прорывом в полость сустава и возникновением гнойного артрита.
- В надкостницу. Это сопровождается ее отслойкой и частым формированием свищей (выход гнойных масс на поверхность кожи через все мягкие ткани, которые окружают воспалительный костный очаг).
- На все структуры кости. Формируется околокостная флегмона с последующим расплавлением окружающих тканей, появлением спаек, контрактур, отека костного мозга.
- Генерализация с поражением других костей, внутренних органов и развитием сепсиса.
Считается, что прорыв гноя в сторону эпифиза или надкостницы является наиболее относительно благоприятным направлением. Генерализация инфекции часто сопровождается развитием системных септических осложнений с нередким летальным исходом.
Подготовка и проведение операции
Определяющую роль в подготовке играет предварительное использование (за 1-2 суток до вмешательства) лечения бактерицидными средствами с учетом антибиотической пробы. Вид и доза антибиотика определяются индивидуально. Раннее начало антибактериального лечения необходимо для предупреждения инфекционно-воспалительных реакций в ходе операции и в раннем послеоперационном периоде.
Бактериальный посев.
Анестезиологическое пособие – важнейшая деталь подготовительного процесса. Его очень аккуратно выбирает анестезиолог после беседы с пациентом, проведенных тестов на аллергию к анестетикам. Невозможно назначить тот или другой тип обезболивания без ясного представления о состоянии здоровья всех органов и систем организма. Поэтому врач-анестезиолог непременно учитывает еще и результаты стандартного обследования, назначаемого всем перед процедурой замены сустава. Выбор методики наркоза зависит от:
- сопутствующих патологий и их тяжести;
- веса и возраста больного;
- локализации проблемного отдела;
- вида и объема протезирования;
- психологического фона пациента.
Пациенту может быть рекомендован общий или регионарный наркоз. Распространенным методом аналгезии, когда нужно заменить сустав ноги, является эпидуральная анестезия. Ее выполняют в строго асептических условиях, при этом анестетик вводится четко в эпидуральное пространство позвоночника, чаще поясничного отдела. Так, вся часть туловища ниже поясницы становится совершенно нечувствительной, но пациент остается в сознании, сохраняется адекватное самостоятельное дыхание.
Накануне оперативного вмешательства назначается обильное питье и стандартное очищение кишечника посредством клизмы. За 8 часов до замены полностью отменяется прием пищи.
Замену сустава проводят в «чистых» условиях операционной со строжайшим следованием всех требований асептики и антисептики (бдительный контроль над стерильностью раны, за своевременной заменой перчаток, инструментов и т. д.). По возможности, хоть это не является самоцелью, хирург должен произвести манипуляции как можно быстрее, но только не в урон качеству имплантации. Быстрое завершение хирургического сеанса позволит минимизировать вероятность развития инфекции.
Немаловажным критерием в сокращении инфекционных рисков выступает малоинвазивность процесса вскрытия костного соединения. Современные операции по поводу замены суставов предполагают именно тактики малотравматичного создания доступа для вживления компонентов эндопротеза, подразумевающие:
- небольшой по длине разрез (6-15 см);
- низкий объем кровопотери;
- корректное обращение с мышцами (их не рассекают, а аккуратно сдвигают);
- отсутствие контакта с нервно-сосудистыми образованиями (опытный ортопед-хирург делает разрез в наиболее безопасном поле).
Что касается самих имплантатов. Больший интерес представляют тотальные или частичные модели с цементной фиксацией. Первостепенно значимо добавлять в цемент антибиотический препарат, который прилагается к имплантируемому изделию или заранее готовится специалистом из наиболее благообразной комбинации медикаментов.
В отдельных случаях целесообразно применять не традиционные протезы суставов, а специальные импланты онкологического типа. Их ставят чаще тогда, когда требуется обширная резекция костных структур. Онкологический эндопротез помогает качественно компенсировать резекционный дефект и добиться отличного восстановления функций протезированного участка. К тому же, онкоконструкции преимущественно выпускаются с напылением серебра, обладающего мощным антибактериальным действием, что усиливает степень противоинфекционной протекции.
Диагностика остеомиелита таза
Диагностика ОТ основывается на анамнестических, клинических данных, а также результатах инструментального обследования больных.
При посттравматическом, послеоперационном и контактном остеомиелите диагноз заболевания, как правило, не вызывал затруднений. Гематогенный же остеомиелит характеризуется наибольшими диагностическими трудностями. Естественно, что это не касается тех случаев, когда на момент госпитализации уже имеются анамнестические данные о заболевании.
Что же бывает причиной диагностических ошибок? Одним из основных клинических симптомов при гематогенном ОТ является боль в области таза, иногда без четкой локализации, зачастую с иррадиацией в нижнюю конечность за счет отека тканей и сдавления нервных стволов. Выраженность этого симптома нередко приводит к госпитализации пациента в неврологическое отделение с диагнозом: корешковый синдром, радикулопатия.
Проводимое лечение обычно не имеет сколько-нибудь значимого эффекта, и в поле зрения хирурга эти больные попадают при развитии параоссальных гнойных осложнений. Но и в этих случаях диагноз остеомиелита далеко не всегда оказывается в дифференциально-диагностическом ряду. При развитии внетазового затека в ягодичную область ошибочный диагноз нередко звучит как постинъекционная флегмона (это весьма актуально с учетом того, что подобные пациенты получают многочисленные внутримышечные инъекции обезболивающих препаратов).
Современная инструментальная диагностика остеомиелита таза базируется на трех китах. Это радиоизотопная сцинтиграфия, магнитно-резонансная томография (МРТ) и компьютерная томография (КТ). Причем каждый из этих методов дополняет другой, а не является альтернативой. Остеосцинтиграфия наиболее информативна при остром гематогенном остеомиелите и обострении хронического. Уже с самого начала заболевания наблюдается повышенное накопление радиофармацевтического препарата (РФП) в очаге поражения, когда структурные изменения в костях еще отсутствуют. Трудно переоценить значение остеосцинтиграфии и при мультифокальном поражении скелета. Количественная оценка накопления РФП при хроническом остеомиелите позволяет объективизировать начало обострения патологического процесса.
Максимальная информативность МРТ связана с возможностью визуализации отека костного мозга, параоссальных мягких тканей, а также гнойных затеков.
Это особенно важно в диагностике внутритазовых гнойников, когда клинических, да ультразвуковых методов бывает недостаточно.
Значимость КТ основывается на возможности детального изучения структурных изменений костей при хроническом остеомиелите: выявлении периостита, зон деструкции, секвестрации кости.
Остеомиелит таза часто сопровождается формированием наружных гнойных свищей.
В этой связи важное место в диагностике отводится фистулографии.
Условия для протезирования сустава
Пациента после остеомиелита послать на замену сустава допустимо лишь в том случае, если одновременно выполняются 3 условия, огласим их.
- Рецидивов гнойного процесса не зарегистрировано в течение минимум 6 мес., в идеале – 2-х и более лет.
- Рентгенографические данные и результаты функциональной диагностики подтверждают необходимость замены сустава (коксартроз последних стадий, порочное положение сочленения, потеря опорных функций, ложный сустав, хромота, др.). Примите к сведению, что одного рентгена бывает недостаточно, поэтому может потребоваться пройти КТ и/или МРТ.
- Лабораторные тесты и вердикты врачебных осмотров не противоречат фундаментальным законам эндопротезирования. А именно, общий анализ крови и мочи, биохимия крови, микробиологические и иммуносерологические тесты, ЭКГ, флюорография легких в норме или в условно допустимых пределах, самочувствие пациента удовлетворительное.
При наличии хронических сопутствующих заболеваний (диабет, гипертония, почечная недостаточность и др.) разрешено проходить вмешательство только после выполненной компенсации заболеваний.

Гнойные выделения из операционной раны.
Все возможные патогенные источники, заметьте, не только в пределах операционного поля, предельно важно элиминировать до операции.
Большое внимание перед протезированием сустава уделяется подавлению патогенной среды, обитающей на слизистых ротовой полости, носа, мочеполовых органов, кишечника и желудка. Почему? Существующая в организме инфекция может транспортироваться с током крови в область имплантации.
Как следствие, спровоцировать местное инфицирование костных и мягких тканей, окружающих эндопротез, в том числе вызвать повторную манифестацию заболевания.
Базируясь на рекомендации некоторых авторов, для ознакомления приведем, как могут выглядеть значения лабораторных анализов (после трехкратного обследования с интервалом в 1 неделю) для допуска к замене сустава после остеомиелита:
- СОЭ – менее 6-8 мм/ч;
- лейкоциты– от 5,5 до 6,0×109;
- нейтрофильные гранулоциты – 50%-58%;
- Т-клетки <61%, В-клетки <23%; О-клетки <21%;
- ИЗФ (фагоцитарная завершенность) – 66,3±2,6;
- Ig классов G и А – не более 140 МЕ/мл, класса М – не выше 200;
- активность комплемента (СН50) – в диапазоне от 25 до 100 ед.;
- СРБ (С-реактивный белок) – 5-12 мг/л;
- антитела к экзотоксину стафилококковому – до 1,0 АЕ/мл.
Если у человека в истории болезней числится остеомиелит, который был полностью вылечен, процент риска интра-, послеоперационной инфекции минимален, не выше 1,5%. То есть при замене сустава пациент рискует точно так же, как те, кто никак не связан с данным диагнозом.
Острый остеомиелит
Признаки острого остеомиелита зависят от пути распространения инфекции, общего состояния организма и степени поражения костей и прилегающих мягких тканей. Визуализационные исследования обычно показывают изменения в течение 2–3 недель после начала заболевания.
Гематогенный остеомиелит обычно возникает у детей, но может быть рецидивом после детства у взрослых. Чаще всего он поражает большеберцовую и бедренную кости, при этом возможно множественное поражение костей.
Воспаление некоторых мягких тканей (например, абсцессы, флегмоны и инфицированные раны) может привести к распространению бактерий в кровеносном русле. В частности, длинные трубчатые кости имеют разветвленную сеть сосудов, проходящих через их среднюю часть, где кровоток значительно медленнее. Это позволяет микроорганизмам оседать в костном мозге и в менее благоприятных условиях (например, при переохлаждении или ослаблении иммунной системы) начинать размножаться, что приводит к гематогенному остеомиелиту. Это заболевание проявляется в трех различных формах.
Септико-пиемическая форма — это острая инфекция, которая начинается быстро и характеризуется тяжелой интоксикацией. Температура у больного может достигать 39–40 °C, появляются озноб, головная боль, тошнота, возможна потеря сознания или судороги. Наблюдается бледность кожи с посиневшими губами и сухость слизистых оболочек. Пульс ускорен, артериальное давление снижено. Заболевание может сопровождаться увеличением селезенки и печени, а также бронхопневмонией. На 1−2-й день болезни в пораженной области возникает резкая локализованная боль, усиливающаяся при движении, появляется отек мягких тканей и красная горячая кожа. При распространении инфекции на близлежащие суставы возможно развитие гнойного артрита.
В течение одной-двух недель в центре поражения формируется очаг скопления жидкости в мягких тканях. Затем гной просачивается в мышцы, образуя межмышечную флегмону. Если ее не вскрыть хирургическим путем, она может вскрыться самостоятельно и привести к образованию свища или перейти в параартикулярную флегмону — гнойный артрит, вызванный инфекцией или сепсисом.
Локализованная форма минимально влияет на общее состояние здоровья, в некоторых случаях состояние человека остается удовлетворительным. Наиболее характерны проявления воспаления как в костях, так и в мягких тканях.
Адинамическая (токсическая) форма встречается реже и известна своим молниеносным началом. На первый план выходят признаки сепсиса: скачки температуры, крайняя степень токсемии, судороги, потеря сознания, резкое падение артериального давления и острая сердечно-сосудистая недостаточность; признаки воспаления костей появляются позже и значительно затрудняют диагностику и лечение.
После открытого перелома может возникнуть посттравматический остеомиелит. Загрязнение раны в момент травмы может привести к развитию этого заболевания. Повышенный риск возникает при наличии оскольчатых переломов, повреждении мягких тканей, других значительных травмах, нарушении кровообращения или снижении иммунитета.
Эта форма инфекции поражает все части кости, но в большей степени распространяется при оскольчатых переломах. Симптомы включают лихорадку, общее недомогание, головную боль и анемию. Кроме того, ткани вокруг места перелома становятся отечными и нежными, из них сочится большое количество гноя.
Особенности воспалительного процесса
Когда бактерии проникают в кость, образуется воспаление, поражающее губчатую ткань кости, надкостницу и костный мозг. Иногда в процесс вовлекаются окружающие мягкие ткани, образуя свищи. Если воспаление развивается внезапно, за 2-3 дня, симптомы его резко выражены, а состояние больного постоянно ухудшается, говорят об остром остеомиелите. При медленном развитии инфекционного поражения возникает хроническая форма заболевания.
При этом воспалительный процесс захватывает все большие участки губчатой костной ткани. Часто развивается некроз костного мозга. Уже через несколько дней после начала заболевания образуются гнойники. Воспаление распространяется на надкостницу и мягкие ткани. Особенно быстро инфекция распространяется в костях бедра и голени. Но если лечение было начато вовремя, воспалительный процесс можно остановить до начала разрушения кости. Такой благоприятный исход болезни чаще всего бывает у детей и молодых людей, у которых она может пройти без следа.
Но иногда происходит омертвение участков костной ткани. Образуются так называемые секвестры. Это участки костной ткани, которые из-за гнойного расплавления отделились от кости. Они окружены гнойным очагом и самостоятельно не рассасываются, особенно с возрастом. Состояние больного ухудшается из-за того, что гнойный очаг нарушает кровообращение. А вследствии из-за недостатка питательных веществ ткани отмирают.
Профилактика воспаления кости
Чаще всего встречается гематогенный или посттравматический остеомиелит. Поражение костной ткани не возникает сразу, обычно ему предшествуют другие инфекционные заболевания или травмы. Поэтому, если принять меры профилактики, воспаления можно избежать
Очень важно сразу обращаться к врачу при появлении симптомов заражения, вовремя лечить хронические заболевания и не допускать наличия в организме очагов инфекции, например, кариеса
Чтобы предотвратить травматический остеомиелит, нужно правильно оказать первую помощь сразу после травмы. При поражении мягких тканей или при открытом переломе кости необходимо обработать рану раствором «Хлоргексидина», ее края смазать зеленкой или йодом и наложить стерильную салфетку. Пораженную конечность нужно обездвижить, а для предотвращения отека и снятия боли к ней можно приложить лед.
Инфекционное поражение костной ткани часто не воспринимается пациентами серьезно. Но при неправильном подходе остеомиелит может привести к инвалидности и даже смерти. Потому нужно внимательнее относиться к своему здоровью и при первых же симптомах воспаления обращаться к врачу.
Современные подходы к терапии
Лечебная тактика зависит от следующих обстоятельств: этиология процесса, патогенность выделенного возбудителя и его устойчивость к терапии, возраст пациента, сопутствующие болезни и наличие осложнений.
Терапия должна быть комбинированной: медикаментозное воздействие, хирургическая помощь, физиолечение и другие вспомогательные методы
Консервативное лечение
В любом случае пациент госпитализируется, проходит тщательное обследование и находится под врачебным контролем на всем протяжении лечебного процесса. В обязательном порядке проводится иммобилизация конечности.
После выделения возбудителя и проверки устойчивости микроба к назначаемым препаратам применяется антибиотикотерапия. Приоритет отдается лекарствам, способным проникать в костную ткань. Часто используют Фузидин, Цефтриаксон, Линкомицин, Ванкомицин. В зависимости от тяжести состояния средства вводятся внутримышечно, внутривенно и в костно-мозговой канал. Как правило, лечебные курсы длятся не менее 30—45 суток, часто со сменой препаратов.
Кроме использования антибиотиков, необходима интенсивная инфузионная терапия с внутривенным введением растворов Гемодеза, Реополиглюкина, Альбумина.
Также назначают препараты из следующих фармакологических групп:
- антисептики — для местной обработки и внутрикостного введения;
- анестетики — для снятия болевого синдрома;
- нестероидные противовоспалительные средства (Диклофенак, Мовалис);
- гипосенсибилизирующие препараты (Пипольфен);
- иммуномодуляторы, в том числе специфические иммуноглобулины.
При подготовке к операции и после нее проводится физиотерапия. В период восстановления необходима лечебная физкультура.
Хирургические способы
Вылечить патологию с помощью консервативных методов удается очень редко, приходится прибегать к помощи хирургов. Возможны следующие виды оперативного вмешательства:
- Вскрытие и дренирование гнойного очага с параллельным введением в костно-мозговой канал растворов антисептиков.
- Удаление секвестров. Проводится в обязательном порядке при обнаружении костных фрагментов на рентгенограмме. Образующиеся после этого полости хирурги-ортопеды заполняют трансплантатами из собственной ткани пациента.
- Ампутация сегмента конечности Особенно касается пальцев у пациентов с сахарным диабетом.
Также удаление части конечности становится необходимостью при долгой иммобилизации, занесении инфекции при установке спиц и других элементов остеометаллосинтеза.
Любая лечебная стратегия должна проводиться на фоне сбалансированной витаминизированной диеты и хорошего ухода.
Возможные осложнения
Патология часто приводит к следующим негативным последствиям:
- костный абсцесс;
- хроническая флегмона костного мозга;
- патологические переломы;
- хронический сепсис с образованием гнойных очагов в разных органах;
- злокачественное перерождение в области поражения.
Прогноз
Полное излечение возможно только на самых ранних стадиях процесса, которые диагностируется крайне редко. При отсутствии активной терапии болезнь начинает быстро прогрессировать. В этом случае прогноз заболевания неблагоприятный, у взрослых иногда оборачивается инвалидностью в связи с ампутацией конечности или ее части.
Особенностью патологии является частый переход в хроническую форму, несмотря на самую современную лекарственную терапию.






